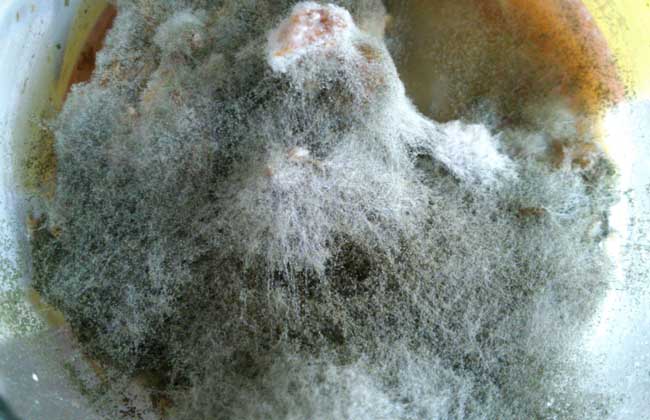

霉菌是丝状真菌的俗称,意即“发霉的真菌”,往往能形成分枝繁茂的菌丝体,但又不象蘑菇那样产生大型的子实体,在潮湿温暖的地方很多物品上长出一些肉眼可见的绒毛状、絮状或蛛网状的菌落就是霉菌,下面我们就一起来看一看霉菌感染是怎么回事吧!
霉菌感染的原因

1、男性包皮内侧是男性染霉菌的理想生长部位,包皮过长是导致男性染霉菌感染的关键原因之一。
2、长期应用广谱抗生素和肾上腺皮质激素,可使霉菌感染大为增加。
3、女性阴道糖原增加、酸度升高时,或在机体抵抗力降低的情况下,可成为致病的原因。
4、青壮年皮脂腺分泌旺盛,外阴潮湿,加之穿较厚的内裤或外阴清洁不够,极易使散落在空气中或寄生在此处霉菌生根发芽,发生感染。
5、当男性在夫妻生活的时候导致皮肤出现损伤的话,则会霉菌感染,而且会传给配偶。
6、维生素缺乏(复合维生素B)、严重的传染性疾病和其他消耗性疾病均可成为白色念珠菌繁殖的有利条件。
7、妊娠期阴道上皮细胞糖原含量增加,阴道酸性增强,加之孕妇的肾糖阈降低,常有营养性糖尿,小便中糖含量升高而促进白色念珠菌的生长繁殖。
霉菌感染的症状
1、女性霉菌感染最常见的症状是白带多,外阴及阴道灼热瘙痒,外因性排尿困难,外阴地图样红斑(霉菌性或念珠菌性外阴阴道炎)。
2、尿频、尿痛、尿道灼热、尿等待、排尿不畅、尿不尽、尿分叉、尿滴白,尿道口流脓、红肿、分泌物增多。
3、男性生殖器红疹、丘疹赘生物、起水疱,会阴及阴囊湿润、瘙痒,阴囊肿大、疼痛,下腹、腹股沟、腰骶疼痛。
4、头晕、失眠、多梦、功能减退、神疲乏力、腰膝酸软。
5、妊娠期霉菌性阴道炎的瘙痒症状尤为严重,甚至坐卧不宁,痛苦异常,也可有尿频、尿痛及性交痛等症状。
霉菌感染怎么办?

1、平时最好不要穿过于紧身的裤子,要保持外阴的干燥清洁。对于用过的衣物,要进行消毒工作,防止再次感染病原体。
2、霉菌常会通过夫妻生活传播,因此患者在治疗期间要禁止夫妻生活。如发现伴侣感染了病菌,一定要同时治疗,否则日后也会交接感染。
3、霉菌性阴道炎还可通过公共厕所、游泳池等公关设施传播,患者在治疗期间应该尽量避免使用公共坐便器,少去公共场所游泳。
4、由于炎症分泌物的浸润,可能会导致外阴骚扰甚至溃疡,患者一定不能盲目使用药物清洗,也不要用手去抓,否则只会加重病情。
5、患者在治疗期间要注意饮食,尽量吃得清淡一些,不要吃辛辣刺激性的食物。
霉菌感染的预防

1、勿过度清洗阴道:在正常的情况下阴道会自己保持酸碱值的平衡,尽量不要以清洁剂或是消毒药水清洁阴道,甚至过度刷洗,这样不仅可能破坏阴道环境的平衡,也有可能造成阴道伤害,所以平时只要以温水冲洗即可。
2、穿棉质通气裤子:平时尽量穿棉质通风的内外裤,保持干爽,平时如果分泌物不多尽量不要用卫生护垫,如果使用就一定要勤更换,以免孳生细菌。
3、少吃刺激性食物:正常情况之下天然免疫系统会自动去应付这些入侵的菌种,所以平时就要有健康均衡的饮食,少吃刺激性的食物,让免疫系统正常运动。
4、切勿滥用抗生素:使用抗生素一定要经过医师的同意与处方,因为抗生素虽然可以杀死细菌,却会助长霉菌的孳生,所以千万不要滥用抗生素。
5、性生活正常单纯:许多阴道疾病的感染途径都是从性行为所传递的,如果性伴侣过多就较难掌控是否感染的情况,所以只要性生活单纯,感染特定的阴道疾病几率就会大大减少。
6、心情要保持愉快:保持心情愉快也是一种增进免疫力的好方法,另外平常的生活作息也要正常,这样才能让免疫系统正常运作。
